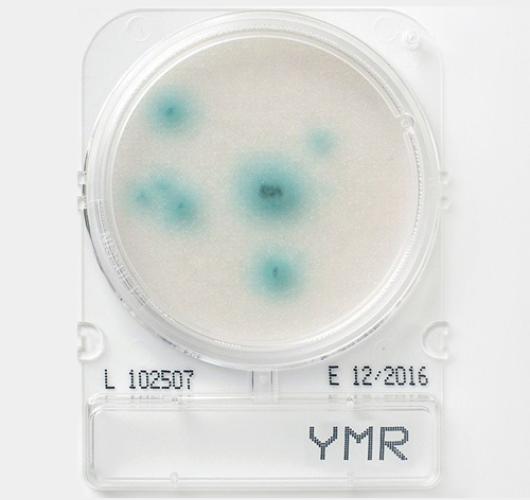

Подложки плесень и дрожжи - Compact Dry YMR
Подложки плесень и дрожжи - Compact Dry YMR
Готовая к использованию сухая хромогенная среда для быстрой идентификации плесневых и дрожжевых грибов. Она содержит хромогенный ферментный субстрат X-Phos, который придает большинству дрожжей синий цвет. Благодаря хромогенным субстратам/окислительно-восстановительным индикаторам микроорганизмы развиваются в определенных цветах, а подсчет колоний осуществляется очень четко. Это сводит к минимуму ошибки персонала, обеспечивая стандартизацию посадки.
Подходит для использования на всех этапах производства и экологического анализа.
Цвет колоний:
Дрожжи: Синий
Плесень: Хлопковая структура с характерным цветом.
Температура и время инкубации: 25–30°C / 48–72 часа.
Срок хранения: 12–18 месяцев / 5–30°C.